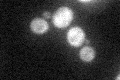
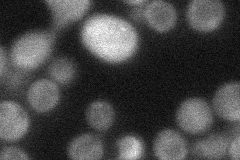
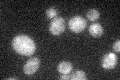

View description
Protein of unknown function, mediates sensitivity to salt stress; interacts physically with the splicing factor Msl1p and also displays genetic interaction with MSL1
Localization:
Intensity:
Fold change:
Significance:
-
C’ GFP library in SD
cytosol32.81 -
N' NOP1pr-GFP in SD

cytosol41.4771 -
N' TEF2pr-mCherry in SD

cytosol17.6245 -
N' NATIVEpr-GFP in SD
cytosol34.7846 -
N' TEF2pr-VC and Cyto-VN in SD

below threshold26.2607 -
C’ GFP library in SD+DTT

technical problem0N/AYes -
C’ GFP library in SD+H2O2

cytosol37.561.14No -
C’ GFP library in Starvation Media
cytosol28.510.86No -
C’ GFP library on the background of Pup2-DaMP

N/A -
C’ GFP library on the background of CCT mutant

N/A0N/AYes
